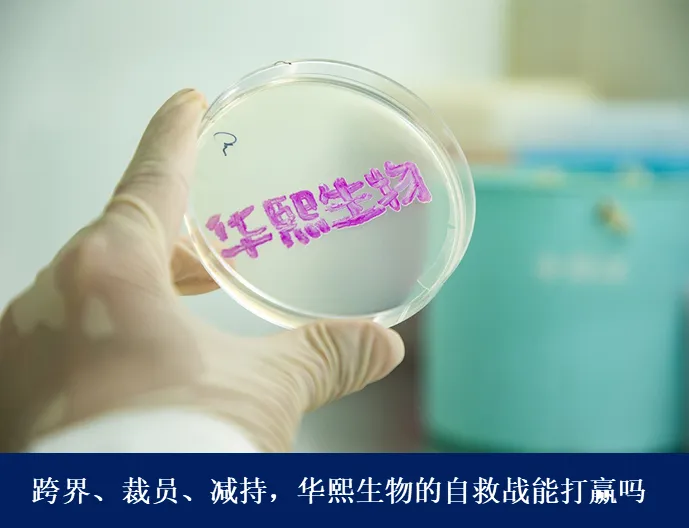

市值跳水千亿,赵燕“刮骨疗毒”能否救华熙生物?观点
1月30日晚间,华熙生物发布2025年度业绩预增预告,预计实现归母净利润2.7亿元至3.2亿元,同比增长54.93%至83.63%。
图源:公司官网
华熙生物传来久违的好消息。
1月30日晚间,华熙生物发布2025年度业绩预增预告,预计实现归母净利润2.7亿元至3.2亿元,同比增长54.93%至83.63%。
然而,盈利改善依然不能掩盖华熙生物增长乏力的问题。
随着玻尿酸红利衰退,公司业绩持续承压。去年3月,“玻尿酸女王”赵燕重返一线,以“壮士断腕”之势对公司业务方向、人才组织进行系统性调整,但成效有限。2025年前三季度,公司营收同比下滑18.4%,归母净利润同比减少30.3%,仅为2.5亿元。
更严峻的是,华熙生物市值较巅峰期已缩水超千亿元。2021年,公司市值飙至1400亿元左右,但截至2025年12月4日收盘,股价击穿发行价,市值较高点蒸发近1200亿元。
雪上加霜的是,8天后华熙生物被踢出科创50指数样本。这就意味着,在官方指数的衡量框架内,其已不再是科创板中最具市场代表性、流动性与成长性的50家公司之一。
调整带来的影响直接而现实。去年四季度以来,部分机构持续减持,其中就包括曾是公司第二大股东的国寿成达。目前该机构持股比例已不足 2%,累计套现金额约4.28亿元
这家曾被誉为“医美茅台”的企业,能否在赵燕的带领下重拾往日荣光?
01
玻尿酸神话为何难续
回看近三年的业绩答卷,华熙生物的营收连年下降态势。
对比2022年巅峰时期63.59亿元的营收规模,2024年营收已降至53.71亿元,下降15.54%;2025年前三季度,公司实现营收31.6亿元,同比进一步下滑18.4%。净利润方面,归母净利润也由2022年的9.71亿元骤降至2024年的1.74亿元,大幅下降82.08%。

数据来源:公司财报
核心原因在于其“现金牛”皮肤科学创新转化业务(原功能性护肤品业务)遭遇业绩滑铁卢。
同花顺iFind数据显示,2022年,该业务一度占据公司七成以上的营收,毛利率更是在80%左右。但自2023年起,营收占比快速下滑。2025年上半年,该业务贡献收入9.12亿元,同比下降33.97%,营收占比降至四成左右,毛利率也下滑至69.7%。
其中的核心品牌润百颜、夸迪、米蓓尔、BM肌活业绩下滑,是拖累该业务增长的主要因素。2024年,上述四大品牌分别实现营收9.23亿元、6.49亿元、2.9亿元、2.79亿元,分别同比下滑了22.63%、41.69%、31.76%、52.06%。
要知道润百颜、夸迪曾均突破10亿元营收,不仅给华熙生物带来直接的业绩增长,也印证了其多品牌运营能力。然而,2024年两个品牌跌破10亿元后,华熙生物彻底退出10亿元玩家俱乐部,业绩增长与发展模式均面临挑战。
核心业务式微,很大程度源于市场竞争环境的剧变。
华熙生物是依托玻尿酸起家,但随着市场参与者增多,其先发优势逐渐被削弱。2025年,国家药监局备案的护肤品中,含玻尿酸产品数量达10562个,接近第二名含烟酰胺产品的两倍。方正证券在2024年的一份研究报告也曾指出:“玻尿酸产品的供应红利期已告一段落,市场呈现供大于求的局面。”
供大于求引发价格内卷,进一步摊薄了企业利润。皮肤科学创新转化业务的疲软,直接导致华熙生物 2024 年净利润暴跌 72.27% 至 1.64 亿元。
尽管原料业务与医疗终端业务在 2024 年实现小幅增长,但规模远不足以抵消核心业务的颓势;进入 2025 年,受行业竞争加剧影响,两项业务收入均出现不同程度下滑。

数据来源:公司财报
此外,产品同质化严重不仅削弱了消费者对玻尿酸的兴趣,其他功能成分的兴起也在分流用户注意力。
过去两年,重组胶原蛋白成为美妆护肤领域新 “吸金王”,带动相关企业业绩爆发:以重组胶原蛋白为核心卖点的巨子生物,2024 年收入突破 50 亿元,实现收入、净利润双增长;锦波生物 2024 年净利润同比增幅超 140%,凭借多款重组胶原蛋白三类医疗器械证切入医美赛道,相关产品已正式上市。
02
“勒紧裤腰带”的自救之路
面对经营挑战与资本市场压力,华熙生物采取 “勒紧裤腰带过日子” 的策略回血。
2025 年前三季度,公司营收下降的同时利润却实现增长,其中第三季度归母净利润同比增长 55.63%—— 这种利润回升并非来自业务扩张,更多源于成本压缩。
一方面,公司调整运营模式,降低销售费用。去年第三季度,华熙生物的销售费用率降至34.26%,为近五年最低。赵燕当时对其解释为“品牌沟通模式与渠道结构优化的结果”。
华熙生物的销售费用此前一直位居高位。这也使得哪怕是营收景气的那几年,华熙生物的盈利能力也并不突出。2023年华熙生物的毛利率为73.32%,落后同是“医美三剑客“之一的爱美客21.77个百分点;净利率更是只有9.59%,在行业中处于垫底的位置。
营收承压后,华熙生物在2025年半年报中表示,正逐步摒弃以往依赖流量和价格促销的投流模式,转向以科学论证为基础的品牌传播逻辑。根据最新公司公告,2025年华熙生物销售费用同比下降超过30%,在收入承压的背景下实现盈利能力持续改善。
也就是说,华熙生物利润增长,很大程度是通过削减广告投放、收缩渠道推广等途径“省”出来的。这种极致的费用控制,也使得去年第三季度经营活动现金流量净额同比大幅增长约8.59倍。
另一方面,华熙生物进行战略收缩,砍掉了与玻尿酸无关的边缘业务。去年第三季度,华熙生物先后关停了儿童护肤品牌润熙禾、护肤品牌润熙泉品牌。

图源:润熙泉微博
华熙生物曾对媒体表示:“润熙泉从来不是华熙生物的主要品牌,也不是主打胶原蛋白的品牌。该品牌的存续对华熙生物的营收和利润贡献没有意义,相关调整是华熙生物聚焦主业和主要品牌的一部分。”
但问题在于,消费者对于几大主品牌的定位也未必清晰。润百颜、夸迪、BM肌活、米蓓尔虽在概念上分别对应修护、抗衰、代谢与敏感肌护理,可在消费者心智中区隔度并不鲜明,彼此差异化价值和市场渗透仍存在一定重叠与模糊。而且,四个品牌都以玻尿酸为支持,较易造成内部竞争稀释资源。
除了精简业务,华熙生物也在精简人员。2024年,华熙生物的在职员工数量为4444名,相较上年末减少211人。去年3月,华熙生物发布的《关于高级管理人员调整及聘任的公告》提到,公司正在进行管理变革,为调整管理架构、精简管理层级,公司决定减少非法定要求的副总经理职位数量。
同年9月,华熙生物因大规模裁员和内部反腐调查再次引发关注。据多名离职员工向媒体透露,公司多条业务线被大幅收缩,其中“肌活”和“米蓓尔”两个团队人数从上百人锐减至仅十几人。短期内裁员与岗位调整加剧了组织震荡。
03
离“生物科技公司”还有多远
然而,勒紧裤腰带过日子无法解决所有难题。
对润熙禾、润熙泉实施战略收缩,留下了此前快速扩张积累的库存压力,仍需一段时间消化。此外,根据公司 2025 年第三季度公告,当期确认资产减值损失 2325.08 万元,其中仅存货跌价准备就计提了 571.30 万元。
与此同时,公司把此前的营销预算投入到研发领域,2025年第三季度研发费用率同比提高3.8%。但研发需要充沛的现金流和漫长的孵化期,华熙生物眼下营收下滑,可以腾挪的资金有限。

数据来源:公司公告
管理变革也带来了额外费用压力。公司最新公告显示,2024 年因组织架构升级、薪酬体系调整、咨询费用及股权激励等相关支出超 7000 万元,影响了短期损益。
更深层次的威胁还在于,高管出走的连带效应是知识外泄、经验断档。华熙生物董事会、监事会、高管层轮番换血,离任或调岗者逾十人;核心科学家郭学平、业务舵手邹松岩等相继离场,研发与业务线瞬间真空,组织的不确定性被瞬间放大,创新链路面临断档风险。
就在传出裁员消息的同时,华熙生物宣布以 1.39 亿港元入股圣诺医药,押注小核酸减脂领域,闯入全球减肥药赛道。
公开资料显示,圣诺医药成立于2007年,2021年在港交所上市,该公司专注于以核酸干扰(RNAi)技术为核心的新药开发,被称为“中国核酸药物第一股”。同时,该公司在医美领域也有布局。
但减肥药赛道早已是红海:国内利拉鲁肽已进入医院渠道,全球市场上礼来、诺和诺德在 GLP-1 领域竞争白热化。华熙生物在此领域几乎没有研发和商业化经验,从股权投资到实现产品盈利,仍有较长距离。
而医美赛道,华熙生物医疗终端业务2025上半年营收同比下降9.44%,至6.73亿元。公司对此解释,“收入小幅下降主要系行业竞争持续加剧,市场扩容速度放缓所致。
除此之外,华熙生物还重投医药、ECM(细胞外基质)等领域,称其希望在业务层面形成多维度协同。去年10月,华熙生物投资了生物医药企业武汉禾元生物科技股份有限公司;发布ECM战略,由旗下品牌润百颜成立“ECM中心”,围绕ECM进行系统性研究与应用布局。

北京“华熙生物·润百颜ECM中心”
图源:华熙生物
多次对外投资使得华熙生物 2025 年前三季度投资活动现金流金额达到 1.21 亿元。尽管公司宣称现金流充裕,但在业绩承压的情况下仍跨界投资多元领域,且投资回报周期未知,可能会拖累核心护肤业务的复苏节奏。
另外,业务跨度较大也容易导致消费者对其 “玻尿酸龙头” 的核心认知淡化,品牌心智趋于模糊。正如“定位之父”杰克·特劳特所言:“能够在潜在顾客心智中建立强大定位的是企业的代表性成就,而非宽泛的产品线。”
赵燕希望用治理红利和研发复利换取长期估值的这条路能否走通,仍需时间检验。
1.TMT观察网遵循行业规范,任何转载的稿件都会明确标注作者和来源;
2.TMT观察网的原创文章,请转载时务必注明文章作者和"来源:TMT观察网",不尊重原创的行为TMT观察网或将追究责任;
3.作者投稿可能会经TMT观察网编辑修改或补充。
